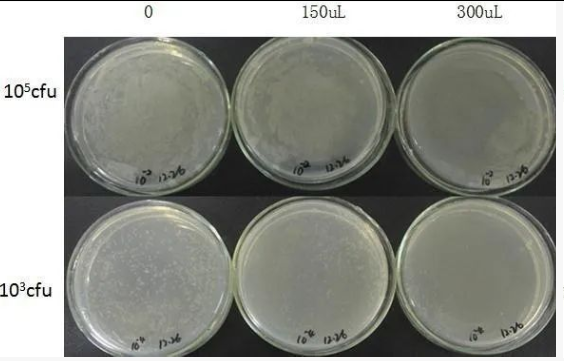
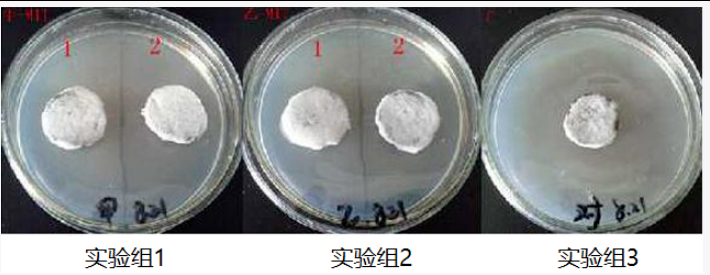

养细胞的人往往谈“污”色变,明明已经小心谨慎,明明已经步步为营,恨不得戴着显微镜操作,发现污染则前功尽弃。除了在操作过程中保证严格无菌以外,做好培养器具的清洁以及预防培养基污染更是至关重要。
如何判断细胞污染?
1、培养基浑浊,可以初步判断是细菌污染。
2、培养基不浑浊,有丝状物质可以初步判断是真菌污染。
3、培养基不浑浊、没有丝状物质,但是细胞状态变差,生长变慢,在显微镜下观察可能会有小黑点,是细胞凋亡坏死,释放出大量碎片,看起来就像黑胶虫,细胞传代以后就出现细胞间黑点,细胞空泡化,很多类似凋亡、坏死的细胞,最终细胞漂浮,完全死亡。

培养环境大扫除
细胞房、培养箱、水盘、水浴锅...除了是细胞生长的温床,同时也是孕育杂菌的温床,因此养细胞之前,我们要对它们进行彻彻底底的大扫除!
Absin为您提供安全、彻底、又高效的除菌全家桶,包含水浴锅抑菌剂(abs9371)、培养箱除菌剂(abs9372)、细胞房除菌剂(abs9373)、水盘抑菌剂(abs9374),由乳链菌肽、纳他霉素、尼泊金酯类、水等组成,无挥发性,分散均匀,热稳定性高。这套试剂能在湿度较大的条件下杀死常见的毛霉、黑霉、青霉、交链孢霉等霉菌孢子,并能抑制大多数的真菌和细菌生长,如大肠杆菌、金黄色葡萄球菌、枯草芽孢杆菌等。

除菌案例:
1、抑制枯草芽孢杆菌
加入除菌试剂后,可以显著抑制枯草芽孢杆菌的生长。
2、抑制霉菌
接种 106 cfu/mL的霉菌至霉菌培养基上,待菌长满后,实验组1、2分别喷洒水浴锅抑菌剂(abs9371)、培养箱除菌剂(abs9372)、细胞房除菌剂(abs9373)、水盘抑菌剂(abs9374),实验组3喷洒无菌水。
喷洒试剂前,

喷洒试剂等待24h后
与常见清洁试剂对比:
|
清洁试剂 |
优劣势 |
|
酒精 |
有刺激性气味,只能用于擦拭物体表面,不可以用于水盘和水浴锅,且只能抑制微生物生长,不能杀灭,要杀灭需要长时间浸泡,已经污染真菌的实验室用酒精消毒效果不明显 |
|
甲醛 |
有刺激性气味有毒致癌 |
|
饱和硫酸铜 |
只能用于水盘且有腐蚀性 |
|
新洁尔灭 |
苯扎溴铵,对革兰阳性细菌作用较强,但对绿脓杆菌、抗酸杆菌和细菌芽孢无效 |
|
84消毒液 |
次氯酸钠,有一定的刺激性与腐蚀性,有挥发性。 |
|
发酵产品、无气味、无刺激性、无毒性、热稳定、无挥发性、安全环保。具有广谱和高效性,对真菌和细菌都有杀灭作用。 |
保卫细胞,消灭支原体
比杂菌污染更棘手的则是支原体污染,它也是是细胞培养领域的一个世界性问题,世界各国细胞系支原体污染的平均比例为30-60%。支原体的直径约为 0.1-0.3μm,这也就意味着它们可以透过常见的滤膜(0.22-0.45μm),因此常规的无菌过滤方法不能将其去除,而常用的抗生素也对支原体无效。

当支原体污染发生后,它们不会使细胞死亡,甚至能与细胞长期共存,也不会使培养基发生浑浊,细胞外观上看起来也不会有明显变化,实际上却埋下了“隐疾”。支原体在潜移默化中悄悄引起细胞变形,影响DNA合成,抑制细胞生长,竞争营养,分泌有害代谢产物,迅速降低培养液中的葡萄糖,形成酸从而改变Ph值;消耗精氨酸、抑制蛋白合成、细胞分裂减慢、停止生长等,最终影响实验结果。
Absin支原体清除试剂&预防试剂
|
类型 |
支原体清除剂 (abs9375) |
支原体预防剂 (abs9376) |
|
有效成分 |
多肽 |
|
|
工作原理 |
1、支原体和细菌带负电荷,多肽带正电荷,互相吸引。 2、多肽作用于支原体细胞膜,使其穿孔,改变渗透压。 3、支原体对渗透压敏感,渗透压的突变可致细胞破裂死亡。 |
|
|
优势 |
1、相较于抗生素类,本品无耐药性 2、无二次污染,随着培养时间的延长,会被缓慢降解为氨基酸 3、细胞毒性小,已在多种细胞上进行过验证 |
|
|
区别 |
·100%清除支原体的污染; ·完全清除支原体,只需3-6天; ·清除血清、培养基中支原体污染;
|
·100%预防支原体的污染; ·广谱性,替代双抗; ·用于预防血清、培养基污染; ·用于发酵、细胞治疗等领域; |
|
使用范围 |
污染后清除支原体,部分敏感细胞,推荐1:2000处理6天 |
培养之前预防支原体污染 |
应用案例:
1、清除猪IPEC-J2细胞中的支原体
支原体清除剂(abs9375)处理猪IPEC-J2细胞3天后,采用Hocest33342染色法对处理前后的细胞进行染色。

2、Absin支原体清除试剂与抗生素类清除试剂对比

400bp左右有条带的为支原体污染。下图是被支原体污染后经支原体清除剂(abs9375)(9、10 条带)和抗生素类试剂(11、12)处理后效果的对比。
相关产品
|
货号 |
品名 |
规格 |
货期 |
|
水浴锅抑菌剂 |
100ml |
现货 |
|
|
培养箱除菌剂 |
480ml |
现货 |
|
|
细胞房除菌剂 |
480ml |
现货 |
|
|
水盘抑菌剂 |
20ml |
现货 |
|
|
支原体清除剂 |
200ul/200ul*5 |
现货 |
|
|
支原体预防剂 |
500ul*4 |
现货 |
往期推荐
Absin·您身边的科研百宝箱
生化试剂:
氨基酸、多肽、核苷/核苷酸、抗生素、碳水化合物、生物缓冲液、表面活性剂、染色剂、酶/辅酶、脂类。
PCR、qPCR、 RT-PCR、mRNA合成、RNA保存、DNA纯化、 RNA 纯化、质粒纯化、连接酶、限制性内切酶、克隆与突变、全基因扩增、核酸电泳、基因调控试剂、CRISPR/Cas9。
细胞冻存、细胞培养、细胞检测、细胞转染、通用试剂、平衡盐缓冲液、清洁产品。
血清:
Apoptosis、Autophagy、Epigenetics、Immunology、NeuronalSignaling、PI3K/Akt/mTOR、PROTACs、TGF-beta/Smad……
抗体、ELISA试剂盒、重组蛋白、WB/IHC/CoIP 常用试剂。
耗材:
载玻片、培养皿、培养板、培养瓶、细胞摇瓶、细胞爬片、细胞过滤器、96孔发光板、磁分选、磁力架、磁标板。
仪器:
实验服务
点击关注多因子实验服务专家
联系我们:爱必信(上海)生物科技有限公司
Tel:021-38015121
E-Mail:info@absin.cn
Web:www.absin.cn




